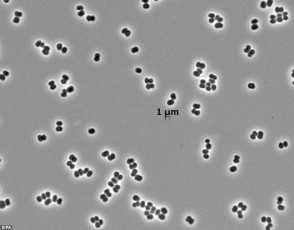

بالصور ... اكتشاف 10 أنواع جديدة من الكائنات الحية في العالم
الاثنين 26 مايو 2014 - 01:39 م
المسلة / اخبار متنوعة
|
بالصور ... اكتشاف 10 أنواع جديدة من الكائنات الحية في العالم

نقلا عن وكالة انباء شينخوا










.jpg)
.jpg)



تعليقات القراء